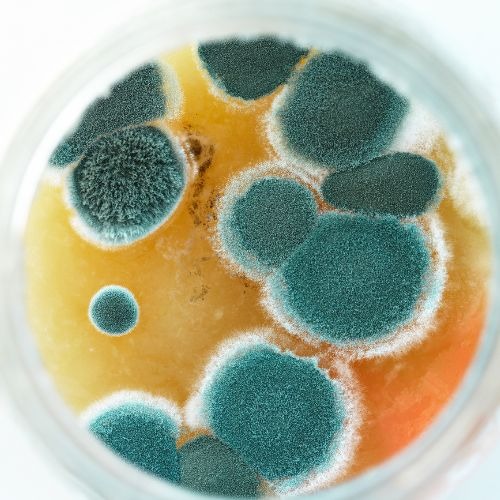

At TNT Wellness, we offer comprehensive functional hormone and nutritional testing to help you achieve optimal health. Our testing provides personalized insights into your hormone balance, nutritional deficiencies, and overall wellness. By identifying imbalances, we create customized plans that address issues like fatigue, weight management, and hormonal health. Whether you’re looking to boost energy, improve digestion, or support long-term wellness, TNT Wellness in Charlotte is here to guide you on your health journey.

TNT Wellness has been a leader in functional health and nutrition for over 30 years, offering personalized and science-based solutions to address a wide range of health concerns. Our comprehensive services, including advanced hormone and gut health testing, bioidentical hormone replacement therapy, and customized wellness coaching, are designed to help you achieve and maintain optimal well-being.
Copyright TNT Wellness 2026